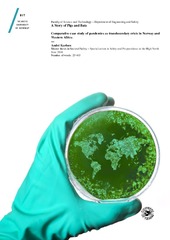

A Story of Pigs and Bats. Comparative case study of pandemics as transboundary crisis in Norway and Western Africa
Permanent lenke
https://hdl.handle.net/10037/9672Dato
2016-06-01Type
Master thesisMastergradsoppgave
Forfatter
Karlsen, AndréSammendrag
The changing nature of crisis and an increased expectancy of pandemics sets the stage for many challenging crisis’ in the future. Modernization and inequalities of a divided world also play a big role in this future, while organizational factors often are the ones being solely blamed for inadequate crisis management. A knowledge gap in combining crisis management literature with pandemic and epidemic response further complicates the ability to plausible predict how health crisis unfold and should be managed.
The main purpose of this thesis is to explore, illustrate and seek a deeper understanding of pandemics through the lenses of crisis management. These lenses will tell the story of modernization, interconnectedness, governance, inequity, health systems, pig, bats, crisis management and an international harvester of blood.
The thesis has been carried out through a comparative case study of H1N1 influenza in Norway and the Ebola outbreak in Western Africa. Reports by the United Nations, the World Health Organization, external management assessors and some news sources have been analyzed though a theoretical framework on transboundary crisis.
Main findings include heavy reliance on the health sector, the World Health Organization as custodians of a crisis, international travel, deforestation, migration, land use, poverty and poor health systems create and facilitate pandemics, and solving a pandemic is in reality the solving of an epidemic in the diseased country. Furthermore, mechanisms for disease propagation, such as “deliberate uncertainty-making”, challenges in mobilizing people, money and goods, stigma associated with being the host country of a disease, lack of awareness of the different international frameworks between the health and humanitarian sectors and the failure to establish an authoritative narrative in communicating disease, have been identified.
The fact that it only takes one infected child to almost force governments on their knees, launching national and international actions to combat an infectious disease, serves as a dire reminder of the importance in incorporating crisis management literature with pandemic and epidemic response.
Forlag
UiT Norges arktiske universitetUiT The Arctic University of Norway
Metadata
Vis full innførselSamlinger
Copyright 2016 The Author(s)
Følgende lisensfil er knyttet til denne innførselen:


 English
English norsk
norsk